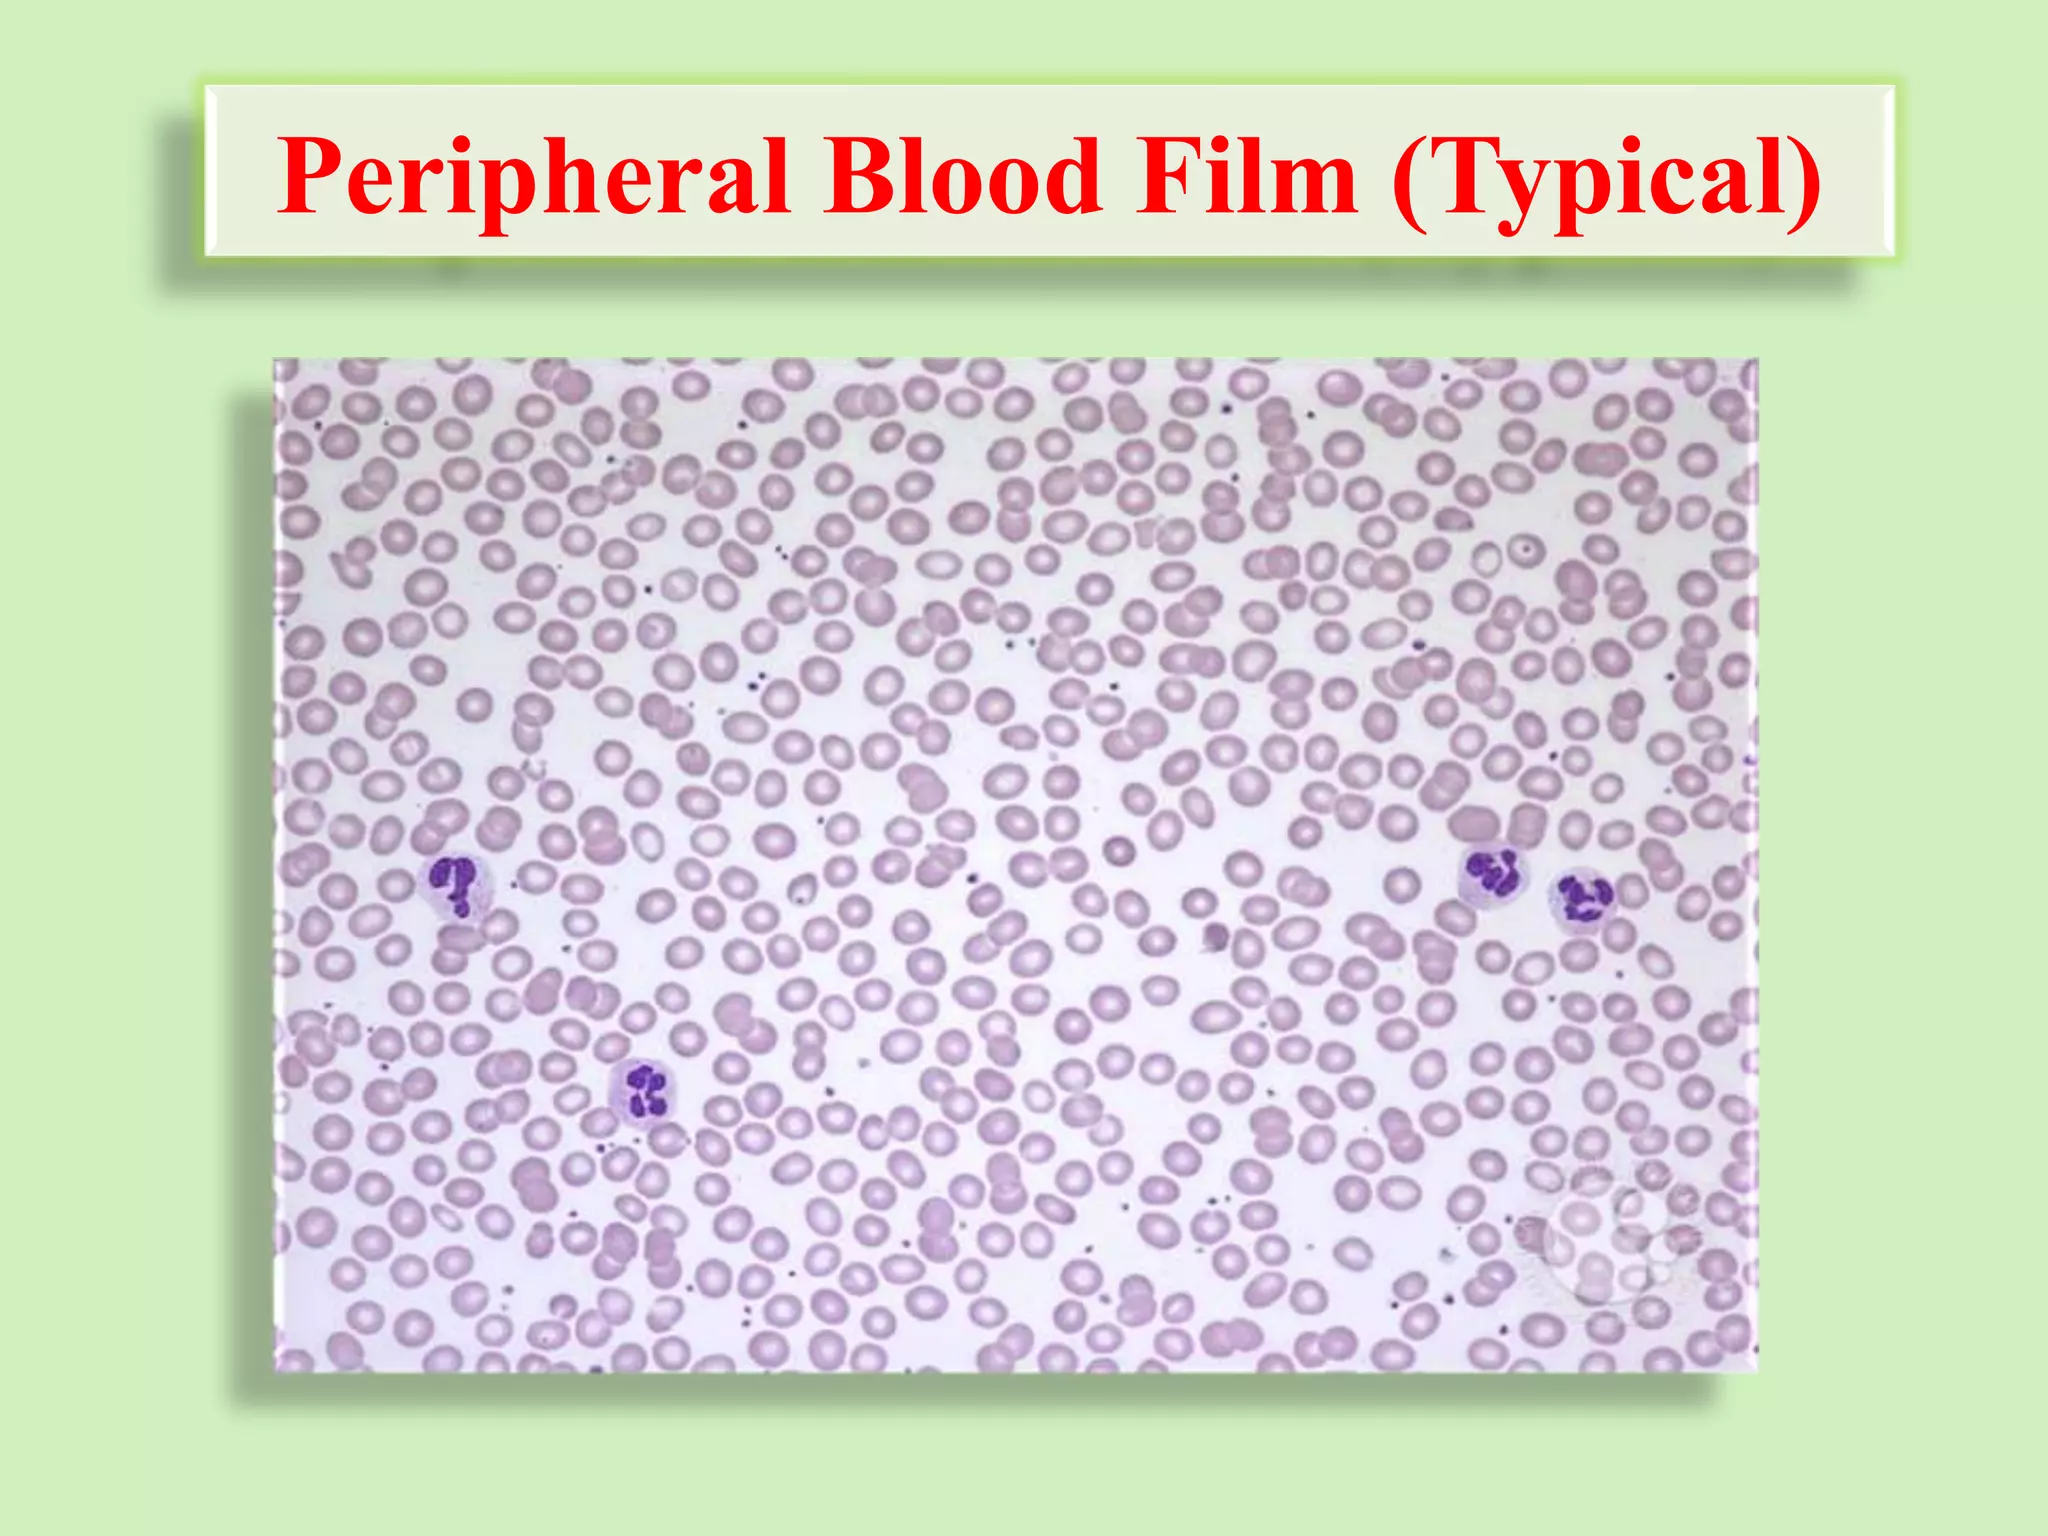
Peripheral Blood Film (Typical)
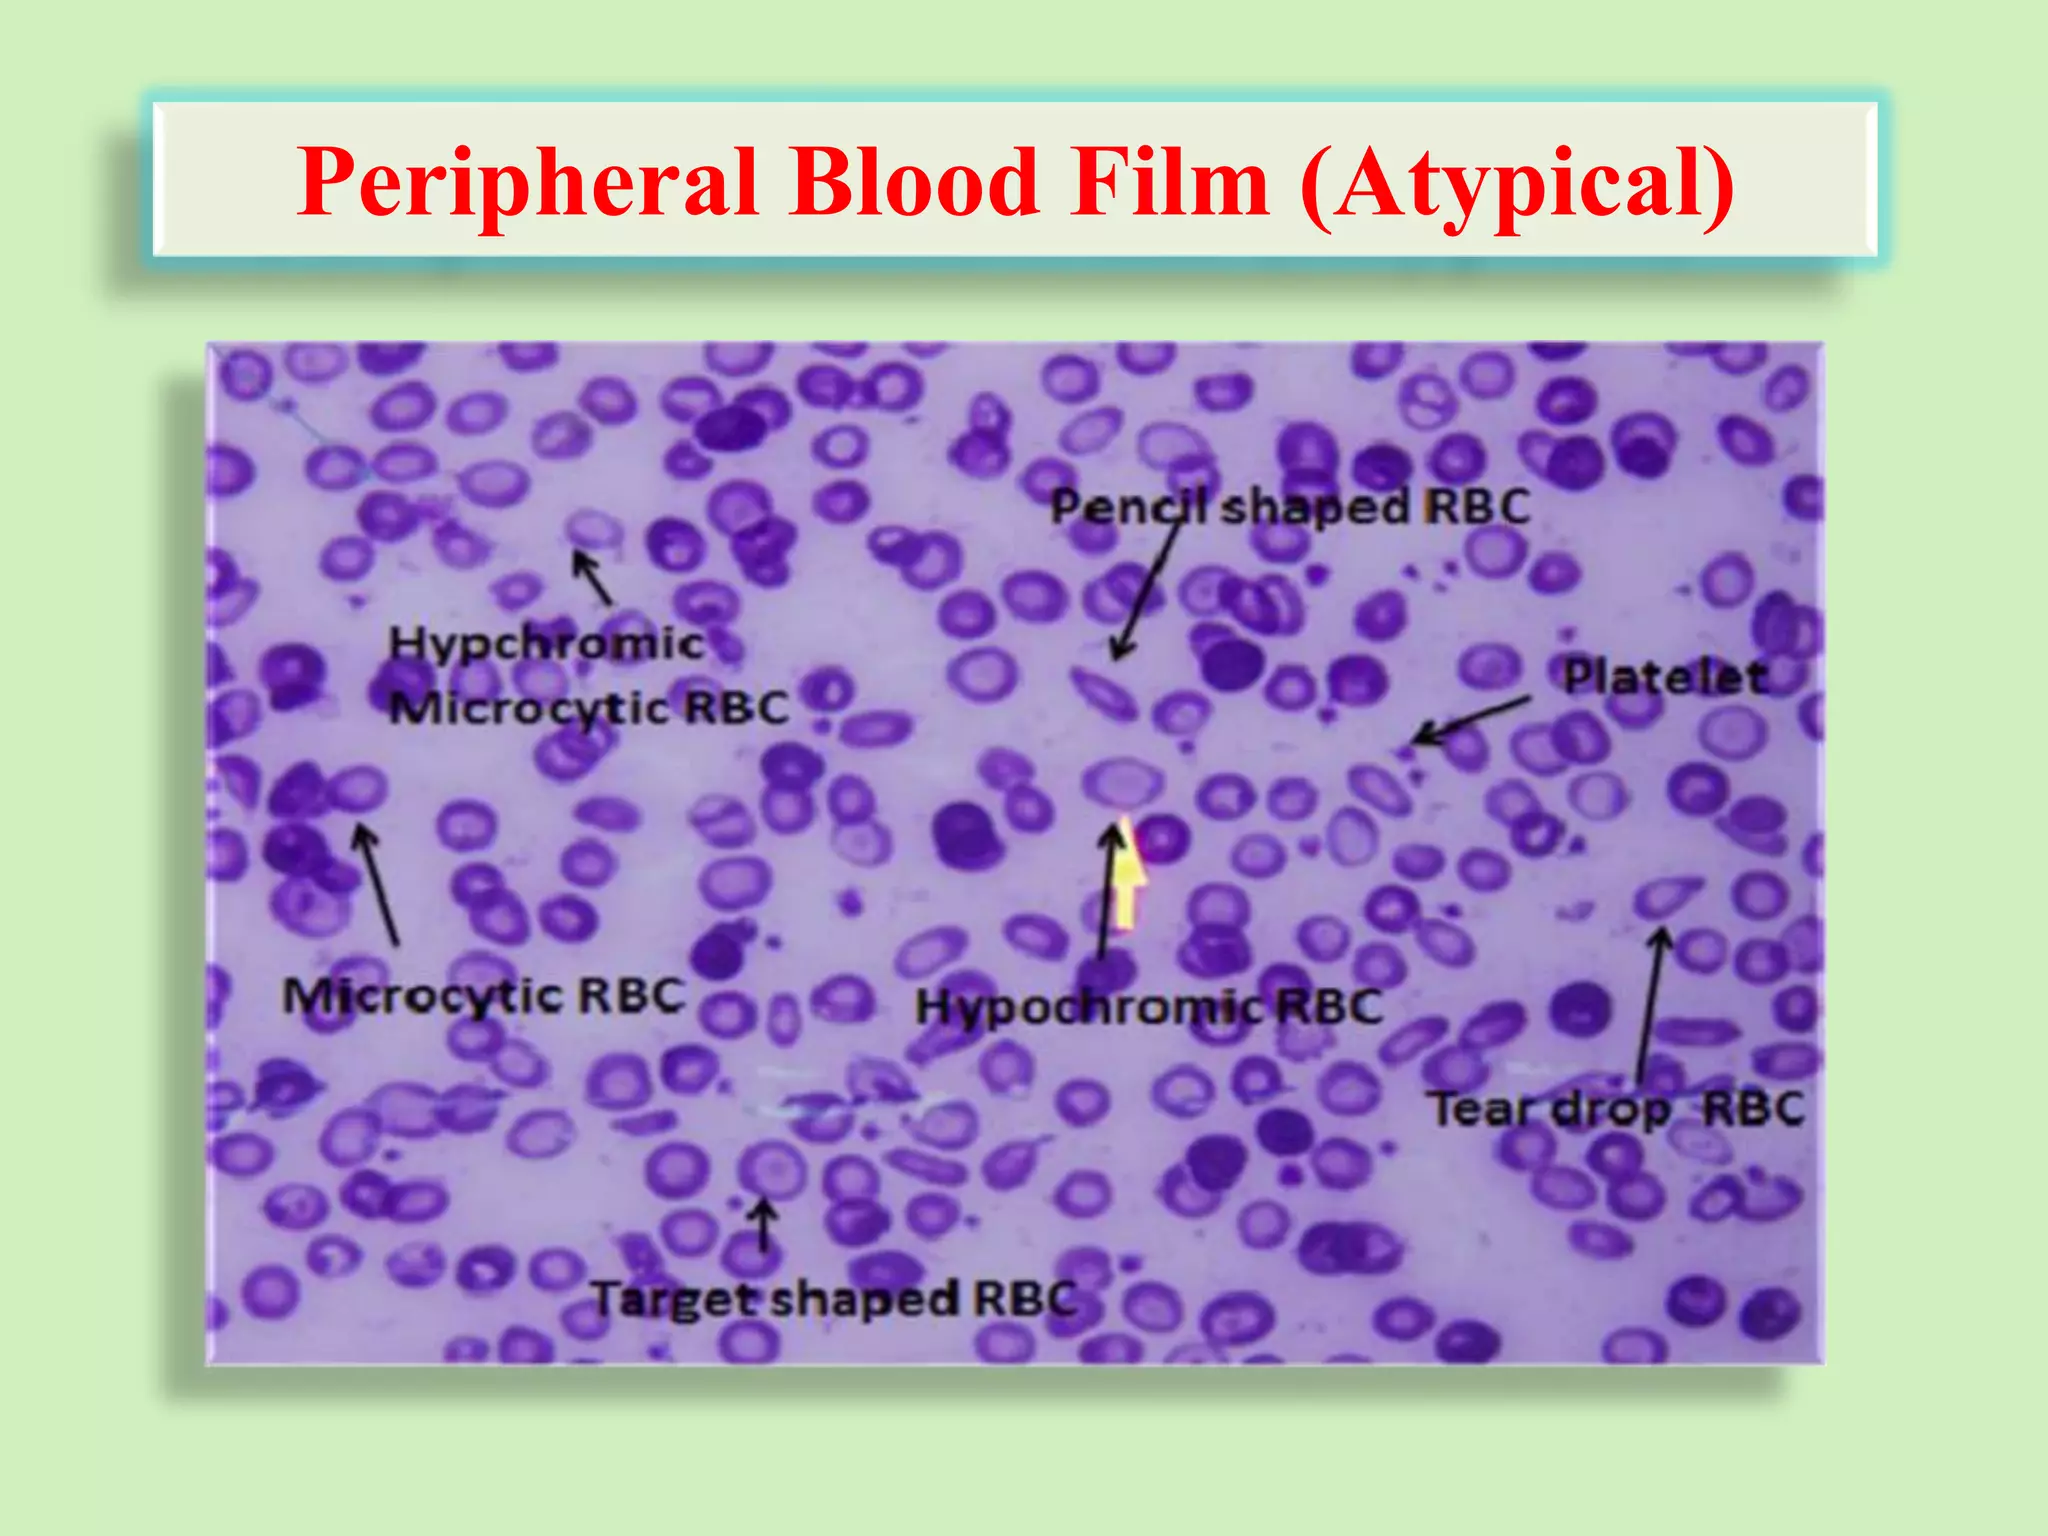
Peripheral Blood Film (Atypical)
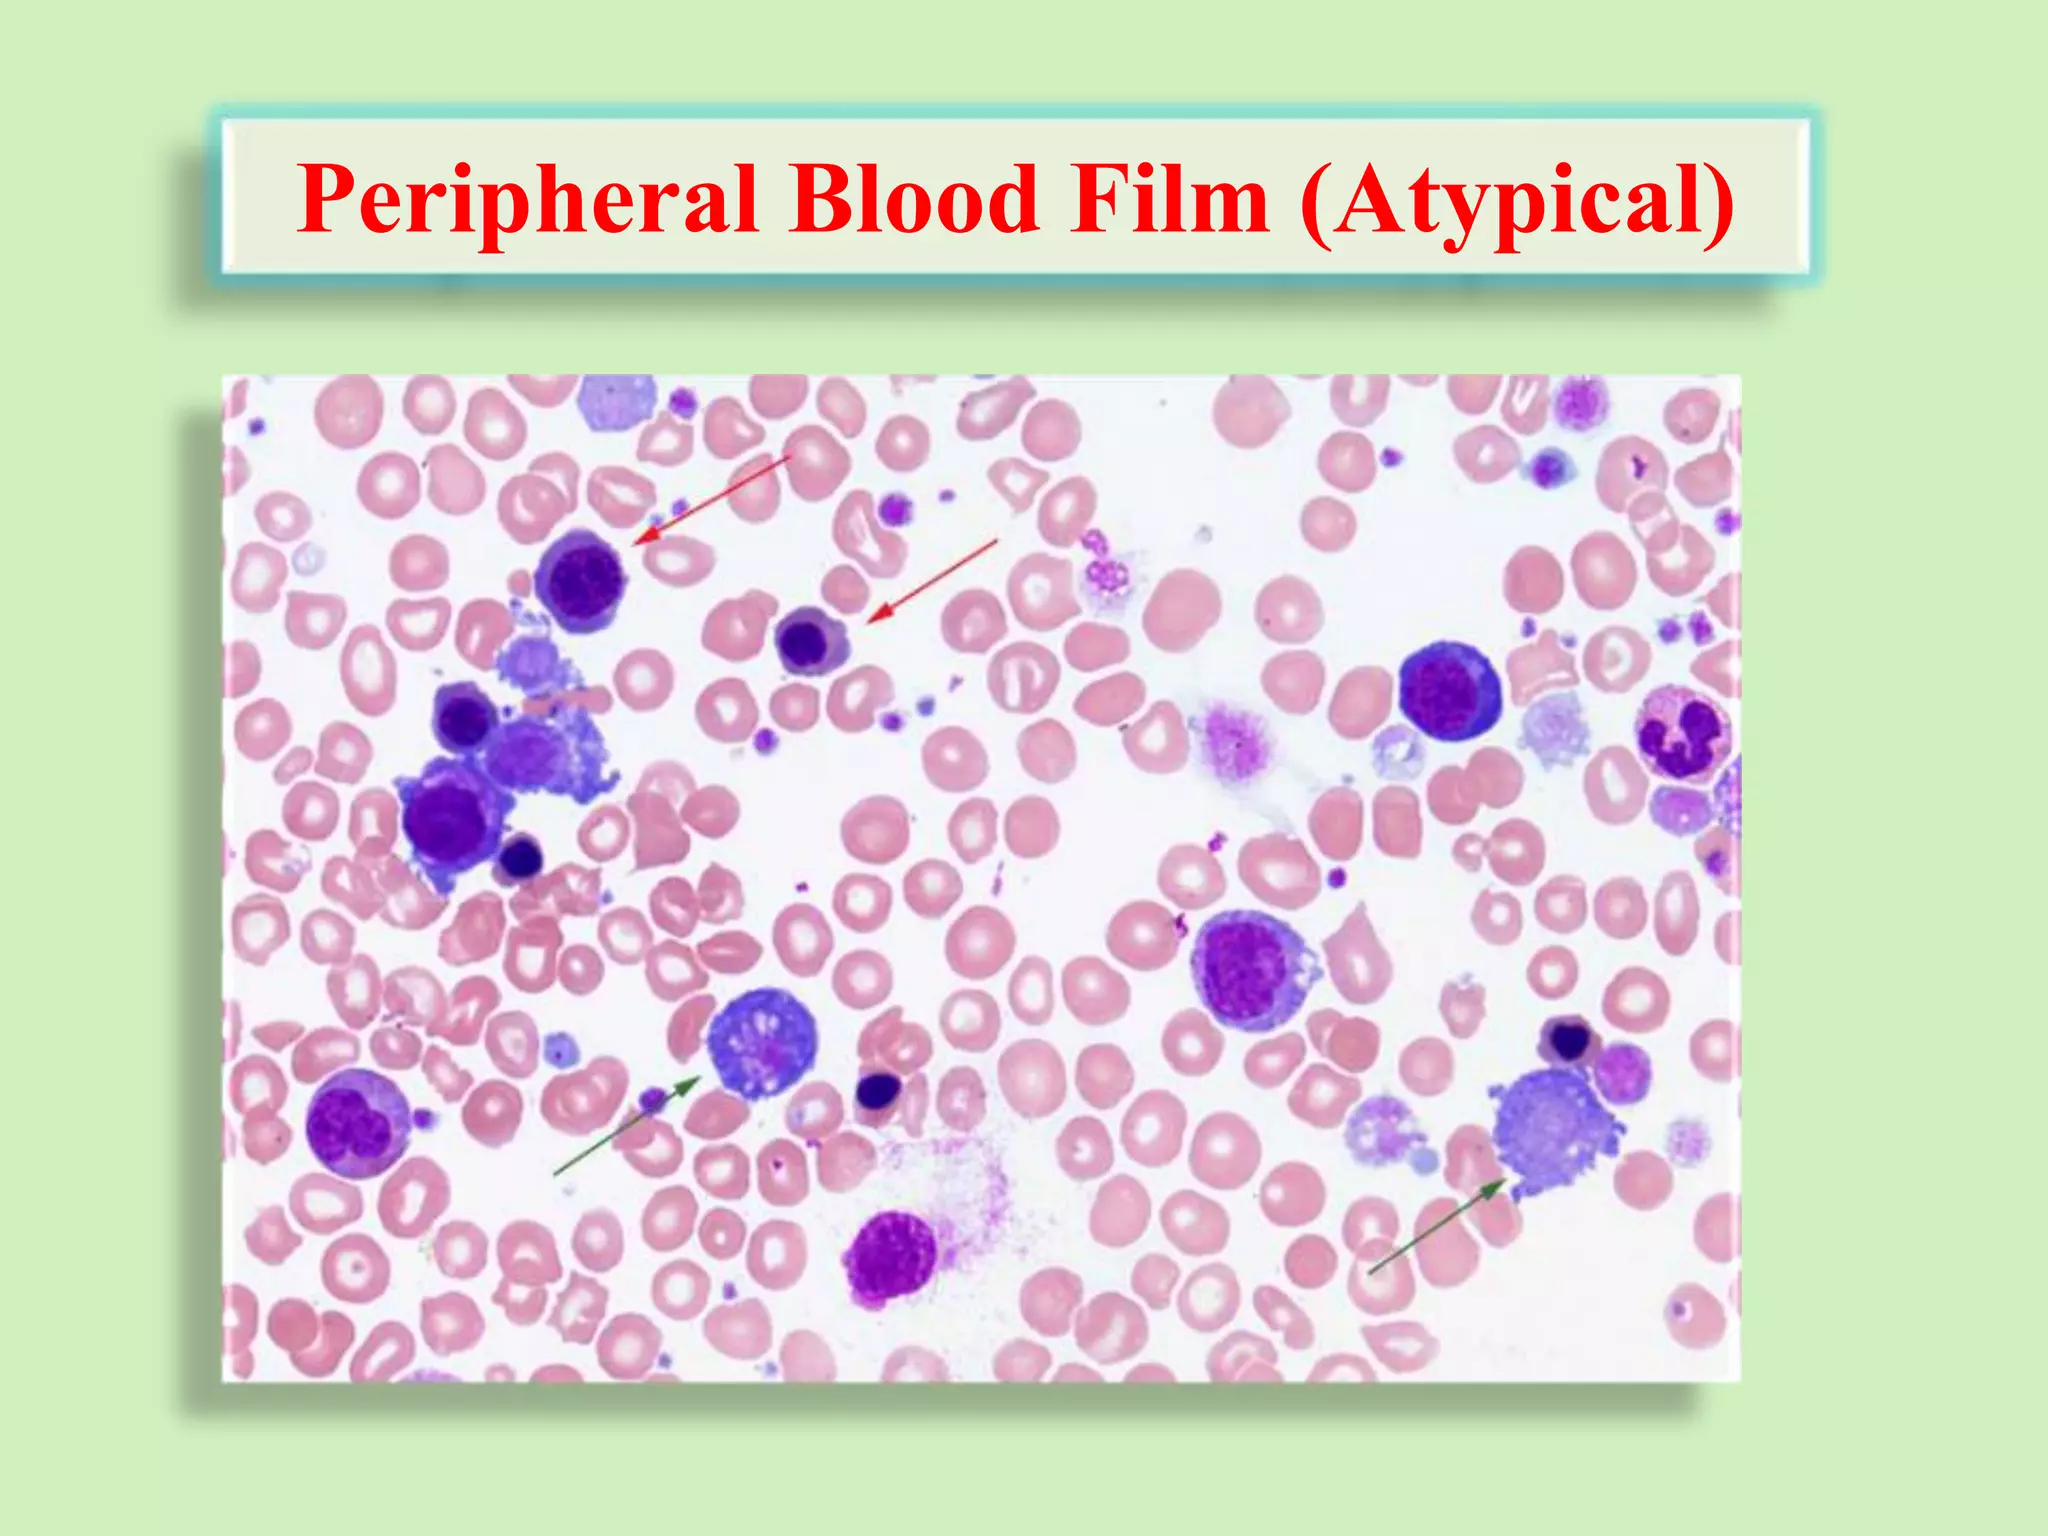
Peripheral Blood Film (Atypical)

1) Automated blood cell counters have evolved from traditional manual counting methods to modern analyzers that can analyze multiple blood parameters from a single sample quickly and precisely.
2) Automated counters minimize errors compared to manual methods by eliminating issues like cell recognition mistakes and distribution errors. They provide results for many parameters not available through manual counting.
3) Modern analyzers can measure parameters like white blood cell, red blood cell, hemoglobin, and platelet counts as well as differentials. This integration of tests saves time compared to running samples separately. Microscopic review is still needed when flags are present.